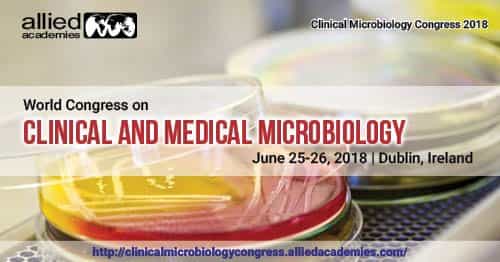
Clinical Microbiology Congress 2018

Clinical Microbiology Congress 2018 is a superb open door for the representatives from Universities and Institutes to associate with the world-class Scientists.
World Microbiology Congress 2018
Clinical Microbiology Congress 2018 means to unite the Professors, researchers, business mammoths, and technocrats to give a global gathering to the spread of unique research comes about, new thoughts and viable improvement and find progresses in the field of clinical and medical microbiology, administration and instruction in connection to clinical and medical microbiology and additionally an expansiveness of different subjects.
Clinical Microbiology Congress 2018 is a superb open door for the representatives from Universities and Institutes to associate with the world-class Scientists.
This meeting makes a stage for Policy-creators, Scientists, agents and leaders in clinical and medical microbiology to display their most recent research and find out about all the imperative advancements in clinical and medical microbiology
If you want to know more about this event or if you want to register, please click the button below.
